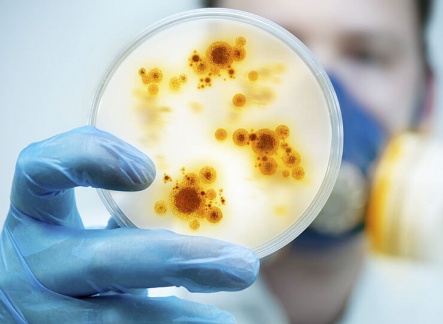

Specialister i kemisk vandbehandling
Kemi-tech ApS arbejder målrettet og engageret indenfor området kemisk vandbehandling.
Hos Kemi-tech har vi længe set behovet på markedet for en stabil samarbejdspartner med de laveste priser på højteknologiske og miljøvenlige specialkemikalier. derudover hjælper vi vore kunder med at optimere driften af deres: dampkedler, kølesystemer og fjernvarmeanlæg, dette resulterer ofte i væsentlige besparelser som 100% tilfalder vore kunder.
Vi samarbejder med førende europæiske specialister på området indenfor udvikling af nye og endnu mere virksomme specialkemikalier og løsninger, Kemi-tech er certificeret efter ISO9001:2015, ISO 14001:2015 og DS/ISO45001:2018 + Bek. 1510:2018 samtidig under størst mulig hensyntagen til vores fælles miljø og energiressourcer.
Her finder du vores:
Vores udgangspunkt er dine behov og ønsker, og vi stiller vores ekspertise til rådighed, så vi i fællesskab kan finde den mest optimale og energibesparende løsning. Du vil derfor opleve vores forretningskoncept som fleksibelt, fair og absolut markedets mest økonomiske.
Vi har fra vores hovedkontor i Danmark, mulighed for at arrangere et besøg lokalt ude på din virksomhed. Direkte fra vores hovedkontor i Danmark eller via vores samarbejdspartnere rundt i Europa.
Vi kommer gerne forbi jeres virksomhed, til en uforpligtende dialog om de fordele, vores koncepter kan tilbyde jer!
Kemi-tech ApS er 100% ejet af Sdiptech AB siden juli 2023.
Sdiptech er en teknologikoncern, der opkøber og udvikler virksomheder inden for ressource optimering sektoren med løsninger, der bidrager til mere bæredygtige, effektive og sikre samfund.
Læs mere om Sdiptech AB
Seneste nyt
Vi har travlt i Kemi-tech. Vi er derfor utrolig glade for at meddele, at vi pr. 1/6-2024 har ansat Thomas Rytlig Makan som Teknisk Direktør. Med Thomas’ ...
On 29 June, Sdiptech AB (publ) announced that the company had entered into an agreement to acquire Kemi-tech ApS, a leading provider in tailored chemic...
Vækst-Invest investerer i Kemi-Tech ApS, en markedsledende virksomhed inden for vandbehandling – med et stort fokus på miljø og miljøvenlige l�...
Åge Thorup kommer til at dække midt- og vestjylland og Klaus Velling kommer til at dække midt- og nordjylland. Åge og Klaus har begge taget kedelpa...
Vi har igen opnået at blive recertificeret. De 3 standarder er gældende for udvikling, handel med kemiske produkter, udstyr samt service til vedligeholde...
Kemi-tech holder åbent. Vores serviceteknikere er stadig klar til servicebesøg og vores produktion er i gang. Forsendelser og levering af varer fortsætter. (...
Moderne kølekondensatorer i galvaniseret stål kræver ekstra fokus på vandkvaliteten, særligt i de første 8 til 12 uger, hvor det anbefales fra producenten...
Jesper Bay Rasmussen• 2.Erhvervskundechef hos Spar Nord Vejle (HD-FR) | Formand for JCI Vejle i 20201d • Redigeret • 1 dag siden ...
Martin er i gang med sit 5. semester af diplomingeniøruddannelsen. Han skal i den kommende periode og frem til januar være en del af Kemi-tech’s udviklings...
Kemi-tech har i en årrække udviklet og testet på en teknologi til at eliminere brugen af biocider som en del af kølevandsbehandlingen, Biocider er som bek...
[video width="1280" height="720" mp4="https://www.dk.kemi-tech.eu/wp-content/uploads/2020/06/15-06-2020-NaOH-BW700.mp4"][/video]...
Vi byder velkommen til vores 2 nye medarbejdere. Salgs- og servicekonsulent Jan Egebo Petersen og Martin Reese Lindbjerg laboratorieassistent og ”blæksprutte...
Vil du høre mere?
Er du interesseret i at høre mere om hvordan Kemi-tech kan hjælpe dig med vandbehandlingsløsninger? Klik på knappen nedenfor, for at se vores kontaktdetaljer.